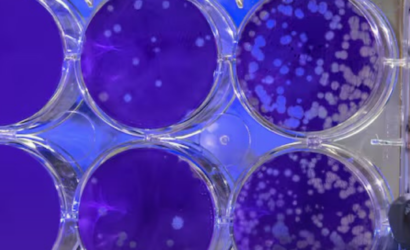
Estas son las células que podrían convertirse en la cura para las enfermedades autoinmunes

El hallazgo de los linfocitos T reguladores, y del gen que los define, hizo a sus descubridores ganar este año…
El sujeto será formalizado esta tarde por el delito de violación con homicidio por lo que enfrentaría una posible condena…
Una trabajadora de una empresa de telecomunicaciones que fue despedida por revisar el WhatsApp de su jefa, grabar una conversación…
Chile atraviesa una transformación demográfica sin precedentes que lo acerca rápidamente a convertirse en un país con «envejecimiento muy avanzado»…
En algunas ocasiones, esas tormentas solares afectan a las comunicaciones en la Tierra y sólo en los casos más extremos…
37 personas murieron luego de la caída de un bus en un barranco en una zona rural del sur de…
Cinco meses prófugo cumplirá Pedro Natalio Ortega Ulloa, un sargento en retiro del Ejército devenido en narcotraficante, que movía los…